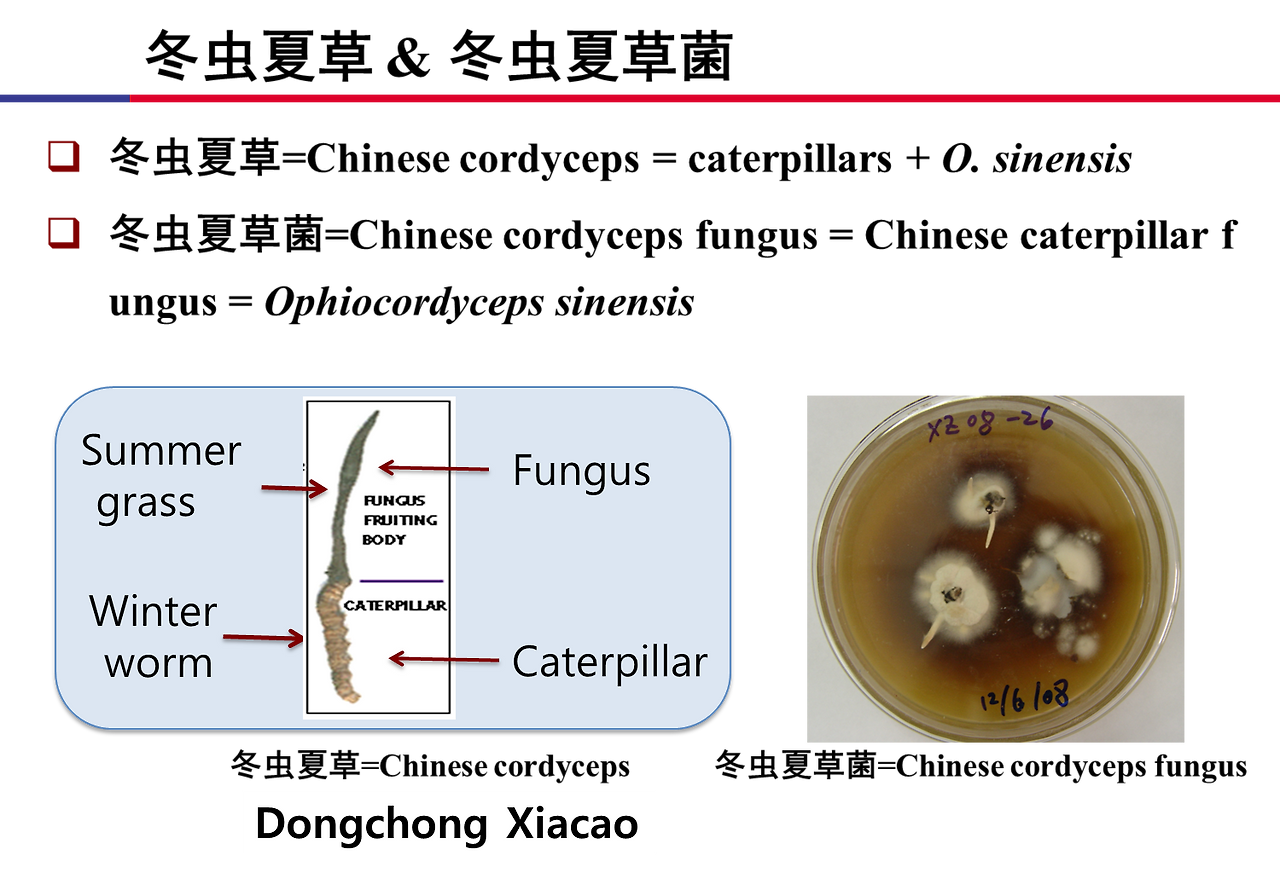
동충하초 3.png

중국의 동충하초(충초) 산업
곰팡이 이야기 20
아시아 균(곰팡이)학회에 참석했다. 전문가에게만 해당되는 세분화된 이야기들이 대부분이었으나 일반인이 관심을 가질 수 있는 발표도 일부 있었다. 그 중에 하나가 중국의 동충하초 연구와 산업에 관한 이야기인데 우리나라에도 관심이 있는 분이 있을 것 같아 소개한다.
원 강의제목은 ‘충초와 충초균(Cordyceps and cordycipitoid fungi)’으로 刘杏忠 (Xingzhong Liu) 박사님(중국과학원 미생물연구소 균류과장, 아시아균학회장, 중국균학회 학술지 Mycology 편집장)이 강의하셨다. 류박사님의 허락을 얻어서 강의 내용의 일부를 제공한다.
미리 말씀드려야 할 것은 나는 동충하초 전문가가 아니며 또한 발표자료에 대하여 깊이 공부할 시간도 없었다. 하지만 책에서도 구할 수 없는 최신자료이므로 이 분야 종사자들에게 도움이 될 것 같아 소개하니 조금 부족하드라도 양해하여 주기 바란다. 내 생각은 최소화하고 가능한 류박사님의 자료를 전달하는데 충실하고자 하였다.
1. 충초(虫草)와 동충하초(冬虫夏草)
충초(虫草, Cordyceps)는 ‘기주인 곤충과 그 위에 자란 곰팡이의 복합체’를 칭한다. 충초균(虫草菌, Cordycipitoid fungus)은 ‘인위적인 배지에 배양된 균사와 자실체 등의 곰팡이’를 말한다.

동충하초(冬虫夏草, Chinese cordyceps)는 중국충초라고도 하며 박쥐나방 유충과 그 위에 자란 곰팡이를 함께 칭한다. 동충하초균(冬虫夏草菌, Chinesecordyceps fungus)은 중국충초균이라고도 하며Ophiocordyceps sinensis 곰팡이를 말한다. 이 곰팡이의 정식 학명은 Ophiocordyceps sinensis (Berk.) G.H. Sung, J.M. Sung, Hywel-Jones & Spatafora 인데 이 학명을 부여한 분은 자랑스럽게도 우리나라의 성재모 (Sung, J.M.), 성기호 (G.H. Sung) 부자이시다.

즉 중국에서는 충초와 동충하초를 구분하여 사용하는데 충초는 Cordyceps를 포함한 다양한 곰팡이(넓은 의미의 Cordyceps 속균)가 자란 다양한 곤충을, 동충하초는 Ophicordyceps sinensis라고 하는 하나의 곰팡이가 자란 박쥐나방을 말한다. 동충하초는 대표적인 충초 중의 하나이다.

충초균은 Hypocreales 목의 3개과(科, family)(Cordycipitaceae, Ophiocordycipitaceae, 일부 Clavicipitaceae)에 속한다.

catalogue of life (www.cataglogueoflife.org/)에 의하면 충초균은 43속 970종에 달한다.

2. 중국의 동충하초 산업
2-1. 자연산 동충하초
동충하초의 기주인 박쥐나방은 유충이 7-9령까지 살며 번데기, 성충과정을 거쳐 다시 알로 태어나는 완전변태를 완성하는데 3-4년이 걸린다. 동충하초균인 Ophiocordyceps sinensis는 여름철에 4-5령의 유충에 침입하여 병 증상없이 가을을 보내고 겨울이 되면 유충의 몸 안을 거득 채운다. 하지만 유충의 형태는 유지하는데, 즉 동충(冬虫)상태를 유지하다가 봄이 되면 자좌가 자라고 6월이 되면 자좌가 모두 자라 하초(夏草)가 된다.

동충하초는 기주인 박쥐나방과 곰팡이인 OPhioc. sinensis의 관계가 매우 섬세하여 일반적으로 인공재배가 불가한 것으로 알려졌었다. 따라서 동충하초의 생장은 중국의 칭하이(60%), 티벳(30%), 쓰촨, 관수, 윤남(10%)의 해발고도 3000-5000m, 위도 26-38도, 경도 80-104도 로 한정되었다. 천연동충하초 시장은 3조 600억 규모로 이 지역의 약 4백만명이 동충하초에 생계를 의존하며 살아가고 있다.

2-2. 동충하초 인공재배
중국은 각고의 노력 끝에 최근에 동충하초의 인공재배에 성공하여 대량 생산을 하게 되었다.

박쥐나방의 3령에 균을 접종하여 약 450일간 배양하여 동충하초를 생산한다.

인공재배한 동충하초는 자연산 동충하초에 비하여 그 성분에 큰 차이가 없는 것으로 일반적으로 여겨진다.

인공재배한 동충하초는 건강기능식품과 화장품 등으로 개발되었으며 2012년 첫 인공재배 이후에 2018년에는 약 5400억원의 수익을 창출하였다.

2-3. 동충하초 균사체 생산
동충하초는 자실체 뿐만이 아니라 균사체로도 재배되고 있으며 이 균사체는 다양한 건강기능식품으로 생산된다. 중국에서 2018년에 약 5100억원의 수익을 창출하였다.

3. 중국의 충초(虫草) 산업
3-1. Paecilomyces hepiali
Paecilomyces hepiali Cs-4는 박쥐나방 유충의 병원균은 아니지만 자연산 동충하초에서 분리되었다. 이 균주의 균사체를 배양하여 금수보(金水宝)라는 제품으로 개발하였는데 2014년 개발이래 2018년까지 4년간 2조 3000억원의 매출을 올린것으로 기록되었다.

3-2. Cordyceps militaris
36개의 건강기능 식품으로 인정되었으며 중국에서 주로 용충초(蛹虫草, 번데기충초)라는 이름으로 판매된다. 중국에서 연 5000억원의 시장을 형성하는데, 한국에서도 생산되며 여러 제품으로 판매된다.

3-3. Isaria cicadae
Isaria cicadae 충초는 1500년 전부터 약용으로 이용되었으며 특히 최근 실험을 통하여 항암작용이 탁월한 것으로 보고되고 있다. 중국에서 蝉花虫草(선화충초, 매미꽃충조)라는 이름으로 널리 판매되고 있다.
4. 맺음말
일본은 황국균(Aspergillus oryzae)을 국균(國菌)으로 정하고 매우 자랑스럽게 생각합니다. 일본이 황국균이 있다고 자랑할 때에 중국이 기가 죽지 않고 자랑하는 곰팡이가 바로 동충하초균(Ophiocordyceps sinensis)입니다. 즉 동충하초균은 중국의 국가대표균입니다.
중국은 중국과학원을 중심으로 동충하초와 충초 연구에 투자하여 괄목할만한 성장을 하였습니다. 단순 분류연구를 떠나서 수조원 대의 시장까지 창출하는데 성공하였습니다. 이제 중국의 균학분야의 기술과 시장은 일본을 넘어섰으며 그 중심에 동충하초가 있습니다.
큰 기대 없이 들은 刘杏忠 (Xingzhong Liu) 박사님의 강의를 거의 전율을 느끼며 들었습니다. 강의 후에 몇가지 질문을 하며 관심을 보였드니 대국인답게 강의자료 파일 전체를 주었습니다. 게다가 한국 사람들과 강의 내용을 공유해도 좋다는 허락까지 받았습니다.
공부하여 자세하게 소개하고 싶지만 일상업무에 들어가면 또 밀려서 언제 빛을 볼지 모르기에 우선 많이 부족하지만 올립니다. 원래 101장짜리 발표자료인데 빠른 이해를 위하여 제가 16장으로 요약하였습니다. 혹시 더 궁금한 자료가 있으면 질문 주시면 나머지 자료에 답변이 있으면 답변드리겠습니다. 그리고 가능하다면 후에 보완도 하겠습니다.
아무쪼록 이 분야의 우리나라의 많은 투자와 발전을 빌어 봅니다.
<본 내용은 필자 개인의 의견을 기록한 것으로써 필자가 소속된 기관의 업무 방향성과는 관련이 없습니다.>
2019. 10. 6. 아시아 균학회 참가 후에